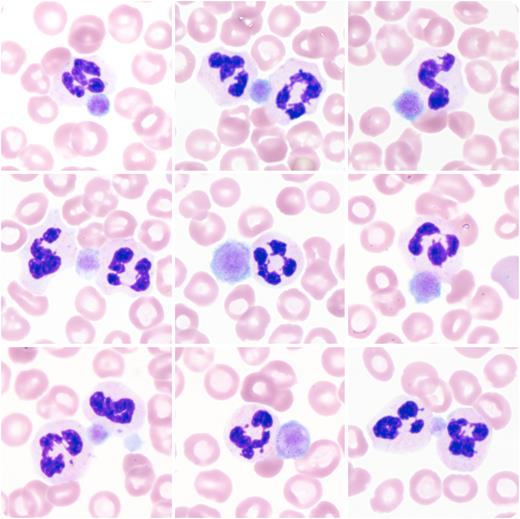
graphic

A 61-year-old patient with a long-standing diagnosis of immune thrombocytopenic purpura (ITP) (having caused a splenectomy 35 years prior) initially presented with symptoms of a newly diagnosed Guillain-Barré syndrome. Despite sequential treatment with IV immunoglobulins (IVIGs) and plasma exchange therapy (PET), the patient’s blood exhibited a decline in platelets (in both EDTA and citrate samples) from 291 × 109/L to 2 × 109/L (reference: 160-370 × 109/L) within 4 weeks. At the nadir, peripheral blood smears showed a near-total absence of platelets, with the remaining (giant) platelets all adhering to neutrophils (collage of 9 fields of view of a peripheral blood smear; magnification ×100).
This phenomenon, called platelet satellitism (PS), is usually interpreted as an EDTA-dependent in vitro phenomenon. Here, it may also represent a correlate of the pathophysiology of the patient’s ITP: Autoantibodies against the glycoprotein IIa/IIIb complex, known to be involved in both ITP and PS, likely mediate the binding between the patient’s platelets and neutrophils. However, antibodies causing PS rarely lead to clinically relevant, “true” thrombocytopenia. Upon treatment with dexamethasone, the platelets transiently rebounded to 129 × 109/L within 5 days. However, the patient continued to experience episodes of ITP, as he did before the described event (despite splenectomy). Therefore, the current episode likely occurred despite, and not triggered by, the treatment with IVIG and PET.
For additional images, visit the ASH Image Bank, a reference and teaching tool that is continually updated with new atlas and case study images. For more information, visit http://imagebank.hematology.org.